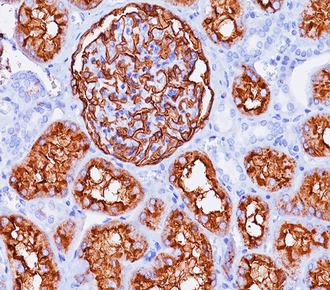
产品封面图

相关产品推荐更多 >
万千商家帮你免费找货
0 人在求购买到急需产品
- 详细信息
- 文献和实验
- 技术资料
- 库存:
99
- 保质期:
已收到实际货物为准
- 供应商:
北京诺博莱德科技有限公司
- 保存条件:
已收到实际货物为准
详细信息:
| 克隆号 : | UMAB235 |
| Ig分类 : | IgG1 |
| 适用组织: | 冷冻切片/石蜡切片 |
| 阳性部位: | 质/膜 |
| 阳性对照: | 子宫内膜间质 |
| 特异性 : | 此抗体可以和人的CD10特异性反应。 |
| 推荐效价: | •原液使用前应以适当比例稀释 推荐稀释度为1:100~1:200 •工作液不必稀释,直接滴加使用 |
风险提示:丁香通仅作为第三方平台,为商家信息发布提供平台空间。用户咨询产品时请注意保护个人信息及财产安全,合理判断,谨慎选购商品,商家和用户对交易行为负责。对于医疗器械类产品,请先查证核实企业经营资质和医疗器械产品注册证情况。
文献和实验Monoclonal Antibody Production
and screening of the hybridomas: 1. Bleeding Mice (1) Place the mouse in a mouse restrainer. (2) Sterilize the tail with 70% ethanol. (3) With a razor blade,nip off the last 2 mm of the tip of the tail. (4) Using a milking motion,pull blood down and let
Monoclonal Antibody Production Protocol
complete with MCM instead of PCM (= IMDM - m ), and keep it in the incubator for fused cells. Isolation of spleen cells Sacrifice mouse by cervical dislocation. Immerse mouse in 70% Ethanol. Remove spleen ( on the left side ) and transfer into a small
monoclonal antibody production fusion
Fusion is an important procedure to produce monoclonal antibodies (MoAb). PROTOCOL prepare the culture of myeloma cells and maintain the concentration of the cells at the level of less than 10
技术资料暂无技术资料 索取技术资料